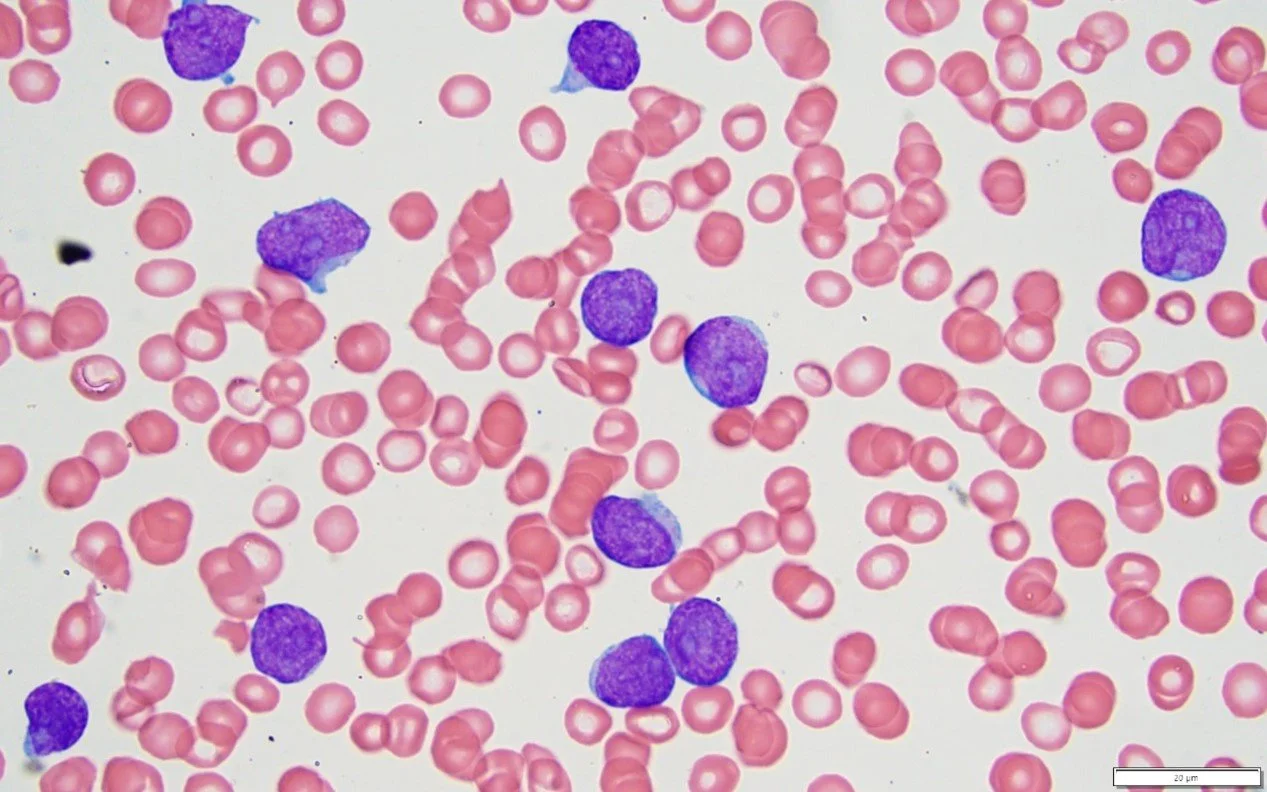

Publicaciones científicas y presencia en eventos académicos
Haz que se destaque.Estudios, artículos o colaboraciones realizadas por miembros de la Sociedad Ecuatoriana de Hematología
-
Primer registro de Leucemia Linfoblástica Aguda en Ecuador
Enviado a la revista Cancer Medicine. Pendiente su publicación, a cargo del Grupo de Leucemias.
-

Hyper-CVAD en pacientes adultos ecuatorianos con Leucemia Linfoblástica Aguda
Artículo enviado a la revista Advanced Hematology. Pendiente su respuesta.
-

Leucemia Linfoblástica tipo T en pacientes ecuatoriano
Artículo remitido y actualmente en proceso de revisión.
Participación en eventos científicos
Avales para:
5th LAG-CLL-2024 (Latin American Group on Chronic Lymphocytic Leukemia), 12 de julio de 2024, realizado 21 y 22 de nov del 2024 en Punta del Este.
"Simposio Híbrido de Hemostasia y Trombosis" del CLATH, 28 de julio de 2024, realizado el 24 de agosto en Quito.
13º Congreso del Grupo Cooperativo Iberoamericano de Medicina Transfusional (GCIAMT), 4º Congreso Iberoamericano de Hematología (SEHH), 6º Congreso de la Sociedad Paraguaya de Hematología y Medicina Transfusional (SPHYMT), 1º Congreso de la Sociedad Paraguaya de Medicina Transfusional y Terapia Celular (SPMTTC). Envío realizado el 15 de noviembre del 2024, que se realizará en Asunción Paraguay del 23 al 26 de abril del 2025.
"2025 Highlights of ASH in Latin America", a celebrarse en Punta del Este, Uruguay, el 25 y 26 de abril de 2025.
Proyectos en colaboración:
Registro Ecuatoriano de Hemoglobinuria Paroxística Nocturna, actualmente en fase de búsqueda de financiamiento.
Participación en el Consenso Andino de hemoglobinuria paroxistica Noctrurna
Presentación de un pre-proyecto al Grupo de Hemofilia Ecuador con el objetivo de desarrollar un registro nacional de esta condición.
Solicitud a MSP para participar en las Guías de Práctica Clínica de Hemofilias.
Relaciones internacionales y acuerdos de cooperación:
Acercamiento con la Sociedad Argentina de Hematología (SAH), octubre 2024, representada por su presidenta, Dra. Juliana Rolón, durante las 5tas Jornadas Latinoamericanas de la SAH. Como resultado, se iniciaron gestiones para obtener becas en los cursos ofrecidos por dicha institución.
Reunión celebrada el 17 de diciembre de 2024, contacto el Grupo PETHEMA. Se acepta la colaboración en el trabajo conjunto el 28 de enero del 2025 para registro de Leucemia Mieloide Aguda, así como en proyectos con el Grupo de Leucemias Ecuador.
Reunión el 7 de diciembre de 2024 de Sociedades de latinoamérica en colaboración con ASH, se comunicaron los programas de auspicio de entrenamiento en ciertas áreas para hematólogos jóvenes en países como Argentina (Fundaleu), Uruguay y México con becas auspiciadas por ASH
Reunión 8 de diciembre con representantes de EHA en el ASH 2024, en el que se abordó la necesidad del registro de enfermedades prevalentes de cada país de Latinoamérica, promoción de investigación, participación de tutoriales en Mar de Plata el 2025 y Chile 2026, promoción de formación de hematólogos jóvenes con pasantías de 3 a 6 meses avalados por EHA.
Aceptación como organización Asociada de American Society of Hematology (ASH), en América Latina, para el 2025 Highlights y se participará en reunión con representantes Latinoamericanos.